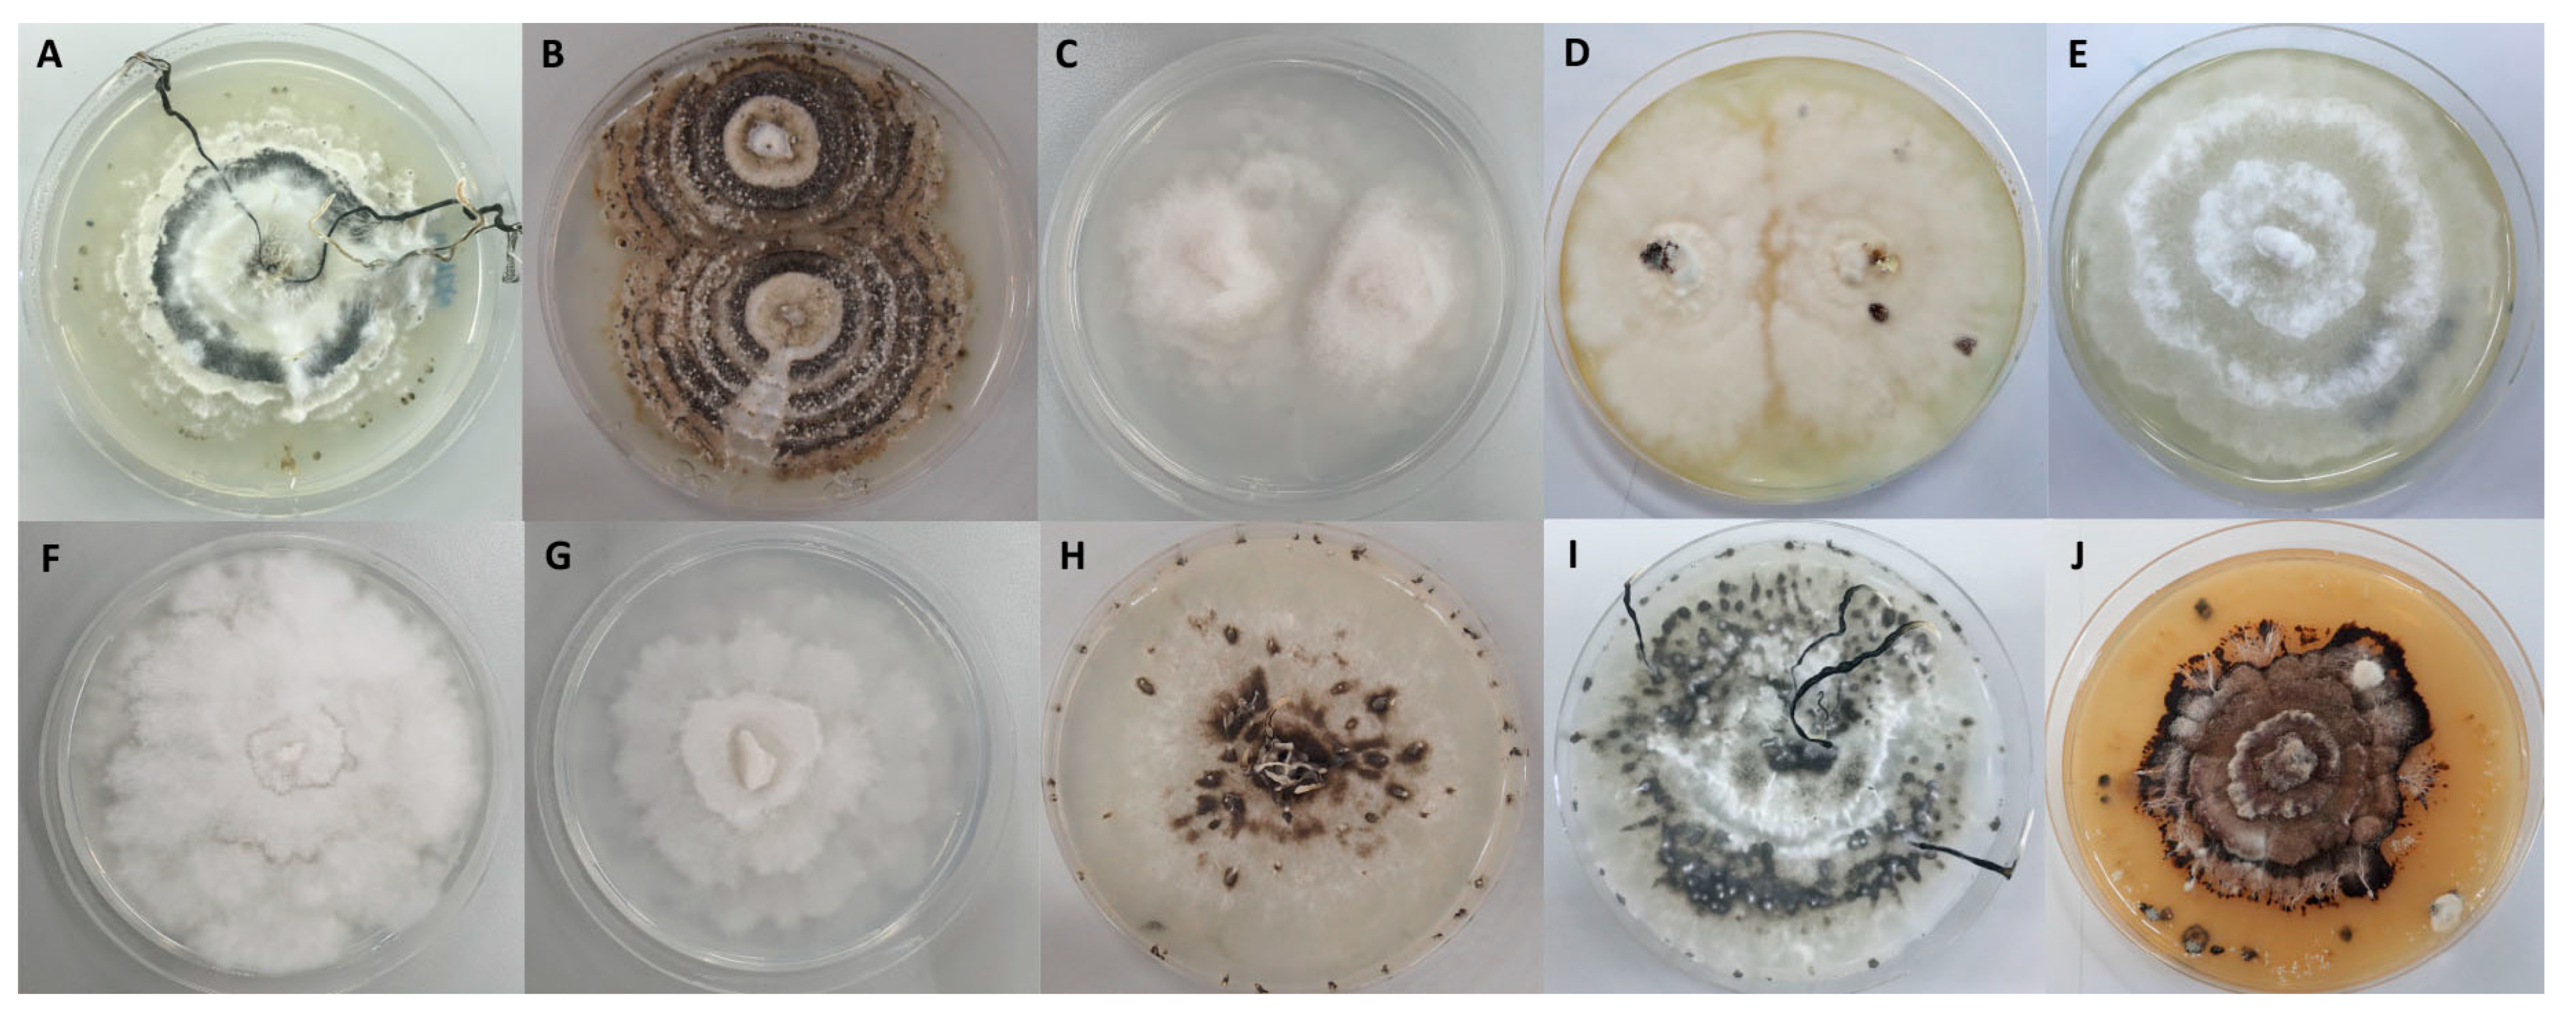

Antioxidant Activity and Cytotoxicity against Cancer Cell Lines of the Extracts from Novel Xylaria Species Associated with Termite Nests and LC-MS Analysis
Abstract
:1. Introduction
2. Materials and Methods
2.1. Chemicals and Reagents
2.2. Fungal Materials
2.3. Fungal Cultivation and Extraction
2.4. DPPH Scavenging Activity
2.5. ABTS Scavenging Activity
2.6. Total Phenolic Content
2.7. Cytotoxicity against Cancer Cell Lines
2.7.1. Cell Culture
2.7.2. Assessment of the Cytotoxicity of Xylaria Species Crude Extracts against Cancer Cell Lines
2.8. Statistical Analysis
2.9. LC-MS Chemical Profiles
3. Results
3.1. Determination of Antioxidant Activities
3.1.1. DPPH Free Radical Scavenging Activity
3.1.2. ABTS Free Radical Scavenging Activity
3.2. Determination of Total Phenolic Content
3.3. Cytotoxicity against Cancer Cell Lines
3.4. LC-MS Chemical Profiles
4. Discussion
5. Conclusions
Supplementary Materials
Author Contributions
Funding
Institutional Review Board Statement
Informed Consent Statement
Data Availability Statement
Acknowledgments
Conflicts of Interest
References
- Valko, M.; Rhodes, C.J.; Moncol, J.; Izakovic, M.; Mazur, M. Free radicals, metals and antioxidants in oxidative stress-induced cancer. Chem.-Biol. Interact. 2006, 160, 1–40. [Google Scholar] [CrossRef]
- Reuter, S.; Gupta, S.C.; Chaturvedi, M.M.; Aggarwal, B.B. Oxidative stress, inflammation, and cancer: How are they linked? Free Radic. Biol. Med. 2010, 49, 1603–1616. [Google Scholar] [CrossRef] [Green Version]
- Ferreira, I.C.; Barros, L.; Abreu, R.M. Antioxidants in wild mushrooms. Curr. Med. Chem. 2009, 16, 1543–1560. [Google Scholar] [CrossRef] [Green Version]
- Collins, A.R. Antioxidant intervention as a route to cancer prevention. Eur. J. Cancer 2005, 41, 1923–1930. [Google Scholar] [CrossRef]
- Chandrasekara, A.; Shahidi, F. Antiproliferative potential and DNA scission inhibitory activity of phenolics from whole millet grains. J. Funct. Foods 2011, 3, 159–170. [Google Scholar] [CrossRef]
- Zhao, G.-R.; Xiang, Z.-J.; Ye, T.-X.; Yuan, Y.-J.; Guo, Z.-X. Antioxidant activities of Salvia miltiorrhiza and Panax notoginseng. Food Chem. 2006, 99, 767–774. [Google Scholar] [CrossRef]
- Latest Global Cancer Data: Cancer Burden Rises to 18.1 Million New Cases and 9.6 million Cancer Deaths in 2018. Available online: https://www.iarc.fr/featured-news/latest-global-cancer-data-cancer-burden-rises-to-18-1-million-new-cases-and-9-6-million-cancer-deaths-in-2018/ (accessed on 29 July 2020).
- Senapati, S.; Mahanta, A.K.; Kumar, S.; Maiti, P. Controlled drug delivery vehicles for cancer treatment and their performance. Signal Transduct. Target. Ther. 2018, 3, 7. [Google Scholar] [CrossRef] [Green Version]
- Sodngam, S.; Sawadsitang, S.; Suwannasai, N.; Mongkolthanaruk, W. Chemical constituents, and their cytotoxicity, of the rare wood decaying fungus Xylaria humosa. Nat. Prod. Commun. 2014, 9, 157–158. [Google Scholar] [CrossRef] [Green Version]
- Sawadsitang, S.; Mongkolthanaruk, W.; Suwannasai, N.; Sodngam, S. Antimalarial and cytotoxic constituents of Xylaria cf. cubensis PK108. Nat. Prod. Res. 2015, 29, 2033–2036. [Google Scholar] [CrossRef]
- Sawadsitang, S.; Suwannasai, N.; Mongkolthanaruk, W.; Ahmadi, P.; McCloskey, S. A new amino amidine derivative from the wood-decaying fungus Xylaria cf. cubensis SWUF08-86. Nat. Prod. Res. 2018, 32, 2260–2267. [Google Scholar] [CrossRef]
- Hu, D.; Li, M. Three New Ergot Alkaloids from the Fruiting Bodies of Xylaria nigripes (Kl.) Sacc. Chem. Biodivers. 2017, 14, e1600173. [Google Scholar] [CrossRef]
- Cong, G.; Jun, L.; Xia, L.; Lin, M.; XiaoHong, Y. Recent advances in the studies of chemical compositions and bioactivities of the genus Xylaria. Mycosystema 2016, 35, 767–781. [Google Scholar]
- Macías-Rubalcava, M.L.; Sánchez-Fernández, R.E. Secondary metabolites of endophytic Xylaria species with potential applications in medicine and agriculture. World J. Microbiol. Biotechnol. 2017, 33, 15. [Google Scholar] [CrossRef]
- Rogers, J.D.; Ju, Y.-M.; Lehmann, J. Some Xylaria Species on Termite Nests. Mycologia 2005, 97, 914–923. [Google Scholar] [CrossRef]
- Ju, Y.-M.; Hsieh, H.-M. Xylaria species associated with nests of Odontotermes formosanus in Taiwan. Mycologia 2007, 99, 936–957. [Google Scholar] [CrossRef]
- Okane, I.; Nakagiri, A. Taxonomy of an anamorphic xylariaceous fungus from a termite nest found together with Xylaria angulosa. Mycoscience 2007, 48, 240–249. [Google Scholar] [CrossRef]
- Hsieh, H.M.; Lin, C.R.; Fang, M.J.; Rogers, J.D.; Fournier, J.; Lechat, C.; Ju, Y.M. Phylogenetic status of Xylaria subgenus Pseudoxylaria among taxa of the subfamily Xylarioideae (Xylariaceae) and phylogeny of the taxa involved in the subfamily. Mol. Phylogenet. Evol. 2010, 54, 957–969. [Google Scholar] [CrossRef]
- Wangsawat, N.; Ju, Y.-M.; Phosri, C.; Whalley, A.J.S.; Suwannasai, N. Twelve New Taxa of Xylaria Associated with Termite Nests and Soil from Northeast Thailand. Biology 2021, 10, 575. [Google Scholar] [CrossRef]
- Lin, Y.; Wang, X.Y.; Ye, R.; Hu, W.H.; Sun, S.C.; Jiao, H.J.; Song, X.H.; Yuan, Z.Z.; Zheng, Y.Y.; Zheng, G.Q.; et al. Efficacy and safety of Wuling capsule, a single herbal formula, in Chinese subjects with insomnia: A multicenter, randomized, double-blind, placebo-controlled trial. J. Ethnopharmacol. 2013, 145, 320–327. [Google Scholar] [CrossRef]
- Ko, H.J.; Song, A.; Lai, M.N.; Ng, L.T. Antioxidant and antiradical activities of Wu Ling Shen in a cell free system. Am. J. Chin. Med. 2009, 37, 815–828. [Google Scholar] [CrossRef]
- Chang, J.C.; Hsiao, G.; Lin, R.K.; Kuo, Y.H.; Ju, Y.M.; Lee, T.H. Bioactive Constituents from the Termite Nest-Derived Medicinal Fungus Xylaria nigripes. J. Nat. Prod. 2017, 80, 38–44. [Google Scholar] [CrossRef]
- Chen, M.-C.; Wang, G.-J.; Kuo, Y.-H.; Chiang, Y.-R.; Cho, T.-Y.; Ju, Y.-M.; Lee, T.-H. Isoprenyl phenolic ethers from the termite nest-derived medicinal fungus Xylaria fimbriata. J. Food Drug. Anal. 2019, 27, 111–117. [Google Scholar] [CrossRef] [Green Version]
- Xiang, Y.; Haixia, W.; Lijuan, M.; Yanduo, T. Isolation, purification and identification of antioxidants from Lepidium latifolium extracts. Med. Chem. Res. 2018, 27, 37–45. [Google Scholar] [CrossRef]
- Almeida, M.M.B.; de Sousa, P.H.M.; Arriaga, Â.M.C.; do Prado, G.M.; de Magalhães, C.E.C.; Maia, G.A.; de Lemos, T.L.G. Bioactive compounds and antioxidant activity of fresh exotic fruits from northeastern Brazil. Food Res. Int. 2011, 44, 2155–2159. [Google Scholar] [CrossRef] [Green Version]
- Rusu, M.E.; Gheldiu, A.-M.; Mocan, A.; Moldovan, C.; Popa, D.-S.; Tomuta, I.; Vlase, L. Process Optimization for Improved Phenolic Compounds Recovery from Walnut (Juglans regia L.) Septum: Phytochemical Profile and Biological Activities. Molecules 2018, 23, 2814. [Google Scholar] [CrossRef] [Green Version]
- Guetchueng, S.T.; Nahar, L.; James Ritchie, K.; Daud Ismail, F.M.; Dempster, N.; Robert Evans, A.; Dey Sarker, S. Four new neo-clerodane diterpenes from the stem bark of Croton oligandrus. Nat. Prod. Res. 2021, 35, 298–304. [Google Scholar] [CrossRef]
- Khan, K.M.; Nahar, L.; Mannan, A.; Arfan, M.; Khan, G.A.; Al-Groshi, A.; Evans, A.; Dempster, N.M.; Ismail, F.M.D.; Sarker, S.D. Liquid Chromatography Mass Spectrometry Analysis and Cytotoxicity of Asparagus adscendens Roots against Human Cancer Cell Lines. Pharmacogn. Mag. 2018, 13, S890–S894. [Google Scholar] [CrossRef]
- Hu, F.; Lu, R.; Huang, B.; Liang, M. Free radical scavenging activity of extracts prepared from fresh leaves of selected Chinese medicinal plants. Fitoterapia 2004, 75, 14–23. [Google Scholar] [CrossRef]
- Siriwach, R.; Kinoshita, H.; Kitani, S.; Igarashi, Y.; Pansuksan, K.; Panbangred, W.; Nihira, T. Xylaropyrone, a new γ-pyrone from the endophytic fungus Xylaria feejeensis MU18. J. Antibiot. 2011, 64, 217–219. [Google Scholar] [CrossRef] [Green Version]
- Yan, S.; Li, S.; Wu, W.; Zhao, F.; Bao, L.; Ding, R.; Gao, H.; Wen, H.A.; Song, F.; Liu, H.W. Terpenoid and phenolic metabolites from the fungus Xylaria sp. associated with termite nests. Chem. Biodivers. 2011, 8, 1689–1700. [Google Scholar] [CrossRef]
- Li, M.; Xiong, J.; Huang, Y.; Wang, L.-J.; Tang, Y.; Yang, G.-X.; Liu, X.-H.; Wei, B.-G.; Fan, H.; Zhao, Y.; et al. Xylapyrrosides A and B, two rare sugar-morpholine spiroketal pyrrole-derived alkaloids from Xylaria nigripes: Isolation, complete structure elucidation, and total syntheses. Tetrahedron 2015, 71, 5285–5295. [Google Scholar] [CrossRef]
- Cho, T.-Y.; Wang, G.-J.; Ju, Y.-M.; Chen, M.-C.; Lee, T.-H. Chemical Constituents from Termite-associated Xylaria acuminatilongissima YMJ623. J. Chin. Chem. Soc. 2016, 63, 404–409. [Google Scholar] [CrossRef]
- Binsan, W.; Benjakul, S.; Visessanguan, W.; Roytrakul, S.; Tanaka, M.; Kishimura, H. Antioxidative activity of Mungoong, an extract paste, from the cephalothorax of white shrimp (Litopenaeus vannamei). Food Chem. 2008, 106, 185–193. [Google Scholar] [CrossRef]
- Divate, R.D.; Wang, C.-C.; Chou, S.-T.; Chang, C.-T.; Wang, P.-M.; Chung, Y.-C. Production of Xylaria nigripes-fermented grains by solid-state fermentation and an assessment of their resulting bioactivity. LWT-Food Sci. Technol. 2017, 81, 18–25. [Google Scholar] [CrossRef]
- Liu, X.; Dong, M.; Chen, X.; Jiang, M.; Lv, X.; Yan, G. Antioxidant activity and phenolics of an endophytic Xylaria sp. from Ginkgo biloba. Food Chem. 2007, 105, 548–554. [Google Scholar] [CrossRef]
- Divate, R.D.; Wang, C.-C.; Chou, S.-T.; Chang, C.-T.; Wang, P.-M.; Chung, Y.-C. Using wheat bran and soybean meal as solid state fermentation substances for the production of Xylaria nigripes with bioactivities. J. Taiwan Inst. Chem. Eng. 2017, 70, 127–133. [Google Scholar] [CrossRef]
- Song, F.; Wu, S.H.; Zhai, Y.Z.; Xuan, Q.C.; Wang, T. Secondary metabolites from the genus Xylaria and their bioactivities. Chem. Biodivers. 2014, 11, 673–694. [Google Scholar] [CrossRef]
- Becker, K.; Stadler, M. Recent progress in biodiversity research on the Xylariales and their secondary metabolism. J. Antibiot. 2021, 74, 1–23. [Google Scholar] [CrossRef]
- McCloskey, S.; Noppawan, S.; Mongkolthanaruk, W.; Suwannasai, N.; Senawong, T.; Prawat, U. A new cerebroside and the cytotoxic constituents isolated from Xylaria allantoidea SWUF76. Nat. Prod. Res. 2017, 31, 1422–1430. [Google Scholar] [CrossRef]
- Gu, W.; Ding, H. Two new tetralone derivatives from the culture of Xylaria hypoxylon AT-028. Chin. Chem. Lett. 2008, 19, 1323–1326. [Google Scholar] [CrossRef]
- Mahavorasirikul, W.; Viyanant, V.; Chaijaroenkul, W.; Itharat, A.; Na-Bangchang, K. Cytotoxic activity of Thai medicinal plants against human cholangiocarcinoma, laryngeal and hepatocarcinoma cells in vitro. BMC Complement. Altern. Med. 2010, 10, 55. [Google Scholar] [CrossRef] [PubMed] [Green Version]
- Liu, J.; He, Y.; Zhang, D.; Cai, Y.; Zhang, C.; Zhang, P.; Zhu, H.; Xu, N.; Liang, S. In vitro anticancer effects of two novel phenanthroindolizidine alkaloid compounds on human colon and liver cancer cells. Mol. Med. Rep. 2017, 16, 2595–2603. [Google Scholar] [CrossRef] [PubMed] [Green Version]
- Stadler, M.; Tichy, H.-V.; Katsiou, E.; Hellwig, V. Chemotaxonomy of Pochonia and other conidial fungi with Verticillium-like anamorphs. Mycol. Prog. 2003, 2, 95–122. [Google Scholar] [CrossRef]
- Liu, G.-K.; Li, N.; Zhang, Y.-J.; Wang, J.-R. LC/MS fingerprint and simultaneous quantification of main bioactive compounds in Polyporus umbellatus (Pers.) Fr. from different regions and developmental stages. Microchem. J. 2019, 144, 351–360. [Google Scholar] [CrossRef]
- de Jesus, J.; Bunch, J.; Verbeck, G.; Webb, R.P.; Costa, C.; Goodwin, R.J.A.; Bailey, M.J. Application of Various Normalization Methods for Microscale Analysis of Tissues Using Direct Analyte Probed Nanoextraction. Anal. Chem. 2018, 90, 12094–12100. [Google Scholar] [CrossRef] [PubMed] [Green Version]
- Edwards, R.L.; Maitland, D.J.; Whalley, A.J.S. Metabolites of the higher fungi. Part 26. Cubensic acid, 3,7,11,15-tetrahydroxy-18-(hydroxymethyl)-2,4,6,10,14,16,20-heptamethyldocosa-4E,8E,12E,16E-tetraenoic acid, a novel polysubstituted C22 fatty acid from the fungus Xylaria cubensis (Mont.) Fr. with substituents and substitution pattern similar to the macrolide antibiotics. J. Chem. Soc. Perkin Trans. 1 1991, 1411–1417. [Google Scholar] [CrossRef]
- Whalley, A.J.S.; Edwards, R.L. Secondary metabolites and systematic arrangements in the Xylariaceae. Can. J. Bot. 1995, 73 (Suppl. 1), S802–S810. [Google Scholar] [CrossRef]
- Adeboya, M.; Edwards, R.L.; Læssøe, T.; Maitland, D.J.; Whalley, A.J.S. Metabolites of the higher fungi. Part 28. Globoscinic acid and globoscin, a labile acid-lactone system from Xylaria globosa and Xylaria obovate. J. Chem. Soc. Perkin Trans. 1 1995, 2067–2072. [Google Scholar] [CrossRef]
- Adeboya, M.O.; Edwards, R.L.; Læssøe, T.; Maitland, D.J.; Shields, L.; Whalley, A.J.S. Metabolites of the higher fungi. Part 29. Maldoxin, maldoxone, dihydromaldoxin, isodihydromaldoxin and dechlorodihydromaldoxin. a spirocyclohexadienone, a depsidone and three diphenyl ethers: Keys in the depsidone biosynthetic pathway from a member of the fungus genus Xylaria. J. Chem. Soc. Perkin Trans. 1 1996, 1419–1425. [Google Scholar] [CrossRef]
- Edwards, R.L.; Maitland, D.J.; Oliver, C.L.; Pacey, M.S.; Shields, L.; Whalley, A.J.S. Metabolites of the higher fungi. Part 31. Longianone, a C7H6O4 spiro bicyclic lactone from the fungus Xylaria longiana (Rehm.). J. Chem. Soc. Perkin Trans. 1 1999, 715–719. [Google Scholar] [CrossRef]
- Guo, C.; Wu, P.; Xue, J.; Li, H.; Wei, X. Xylaropyrones B and C, new γ-pyrones from the endophytic fungus Xylaria sp. SC1440. Nat. Prod. Res. 2018, 32, 1525–1531. [Google Scholar] [CrossRef]
- Tang, J.; Wang, X.C.; Hu, Y.; Ngo, H.H.; Li, Y.; Zhang, Y. Applying fermentation liquid of food waste as carbon source to a pilot-scale anoxic/oxic-membrane bioreactor for enhancing nitrogen removal: Microbial communities and membrane fouling behaviour. Bioresour. Technol. 2017, 236, 164–173. [Google Scholar] [CrossRef] [PubMed]
- Li, M.; Chen, X.; Che, X.; Zhang, H.; Wu, L.-P.; Du, H.; Chen, G.-Q. Engineering Pseudomonas entomophila for synthesis of copolymers with defined fractions of 3-hydroxybutyrate and medium-chain-length 3-hydroxyalkanoates. Metab. Eng. 2019, 52, 253–262. [Google Scholar] [CrossRef] [PubMed]
- Guo, H.; Kreuzenbeck, N.B.; Otani, S.; Garcia-Altares, M.; Dahse, H.-M.; Weigel, C.; Aanen, D.K.; Hertweck, C.; Poulsen, M.; Beemelmanns, C. Pseudoxylallemycins A–F, Cyclic Tetrapeptides with Rare Allenyl Modifications Isolated from Pseudoxylaria sp. X802: A Competitor of Fungus-Growing Termite Cultivars. Org. Lett. 2016, 18, 3338–3341. [Google Scholar] [CrossRef] [PubMed]
- Helaly, S.E.; Thongbai, B.; Stadler, M. Diversity of biologically active secondary metabolites from endophytic and saprotrophic fungi of the ascomycete order Xylariales. Nat. Prod. Rep. 2018, 35, 992–1014. [Google Scholar] [CrossRef]
- Jirakkakul, J.; Punya, J.; Pongpattanakitshote, S.; Paungmoung, P.; Vorapreeda, N.; Tachaleat, A.; Klomnara, C.; Tanticharoen, M.; Cheevadhanarak, S. Identification of the nonribosomal peptide synthetase gene responsible for bassianolide synthesis in wood-decaying fungus Xylaria sp. BCC1067. Microbiology 2008, 154, 995–1006. [Google Scholar] [CrossRef] [Green Version]
- Abate, D.; Abraham, W.-R.; Meyer, H. Cytochalasins and phytotoxins from the fungus Xylaria obovata. Phytochemistry 1997, 44, 1443–1448. [Google Scholar] [CrossRef]
- Zhang, Q.; Huang, Z.P.; Zhao, Y.Y.; Zhao, Q.; Chen, J.H.; Ma, W.G.; Zhang, X.M. Six 19,20-epoxycytochalasans from endophytic Diaporthe sp. RJ-47. Nat. Prod. Res 2020, 1–6. [Google Scholar] [CrossRef]
- Kumarihamy, M.; Ferreira, D.; Croom, E.M., Jr.; Sahu, R.; Tekwani, B.L.; Duke, S.O.; Khan, S.; Techen, N.; Nanayakkara, N.P.D. Antiplasmodial and Cytotoxic Cytochalasins from an Endophytic Fungus, Nemania sp. UM10M, Isolated from a Diseased Torreya taxifolia Leaf. Molecules 2019, 24, 777. [Google Scholar] [CrossRef] [Green Version]
- Chao, W.-W.; Lin, B.-F. Isolation and identification of bioactive compounds in Andrographis paniculata (Chuanxinlian). Chin. Med. 2010, 5, 17. [Google Scholar] [CrossRef] [Green Version]
- Alam, M.A.; Subhan, N.; Rahman, M.M.; Uddin, S.J.; Reza, H.M.; Sarker, S.D. Effect of citrus flavonoids, naringin and naringenin, on metabolic syndrome and their mechanisms of action. Adv. Nutr. 2014, 5, 404–417. [Google Scholar] [CrossRef]
- Zhao, Z.; Zheng, N.; Wang, L.; Hou, Y.; Zhou, X.; Wang, Z. Rottlerin exhibits antitumor activity via down-regulation of TAZ in non-small cell lung cancer. Oncotarget 2017, 8, 7827–7838. [Google Scholar] [CrossRef] [PubMed] [Green Version]
- Wang, L.; Hou, Y.; Yin, X.; Su, J.; Zhao, Z.; Ye, X.; Zhou, X.; Zhou, L.; Wang, Z. Rottlerin inhibits cell growth and invasion via down-regulation of Cdc20 in glioma cells. Oncotarget 2016, 7, 69770–69782. [Google Scholar] [CrossRef] [PubMed]
- Corrêa, W.R.; Serain, A.F.; Aranha Netto, L.; Marinho, J.V.N.; Arena, A.C.; de Figueiredo Santana Aquino, D.; Kuraoka-Oliveira, Â.M.; Júnior, A.J.; Bernal, L.P.T.; Kassuya, C.A.L.; et al. Anti-Inflammatory and Antioxidant Properties of the Extract, Tiliroside, and Patuletin 3-O-β-D-Glucopyranoside from Pfaffia townsendii (Amaranthaceae). Evid.-Based Complement. Altern. Med. 2018, 2018, 6057579. [Google Scholar] [CrossRef] [PubMed] [Green Version]
- Nowak, R. Separation and Quantification of Tiliroside from Plant Extracts by SPE/RP-HPLC. Pharm. Biol. 2003, 41, 627–630. [Google Scholar] [CrossRef]
- Üçel, I.U.; Can, Ö.D.; Demir Özkay, Ü.; Ulupinar, E. Antiamnesic effects of tofisopam against scopolamine-induced cognitive impairments in rats. Pharmacol. Biochem. Behav. 2020, 190, 172858. [Google Scholar] [CrossRef] [PubMed]
- Pattnaik, J.i.; Deepthi, R.A.; Dua, S.; Padhan, P.; Ravan, J.R. Role of Tofisopam in Post COVID Neuro-psychiatric Sequelae: A Case Series. Indian J. Psychol. Med. 2021, 43, 174–176. [Google Scholar] [CrossRef]

| Species | Isolation ID. | Peak No.* | Identified Compound |
|---|---|---|---|
| X. chaiyaphumensis | SWUF16-4.1 | 1, 2, 3, 33, 54, 55, 57, 58, 59, 60 | prednisone (1), xylaropyrone (2), bassianolide (59) |
| X. chaiyaphumensis | SWUF16-11.4 | 1, 2, 3, 12, 26, 30, 33, 35, 38, 44, 50, 55, 56, 57, 60 | prednisone (1), xylaropyrone (2), 4′-O-(2′-Z-feruloyl GluA(1-2)GluA) apigenin (50) |
| X. chaiyaphumensis | SWUF17-49.2 | 1, 2, 3, 23, 47, 52, 54, 55, 57, 58, 59, 60 | prednisone (1), xylaropyrone (2), euphyperin B (23), animicin A (47), bassianolide (59) |
| X. subintraflava | SWUF16-11.1 | 1, 2, 3, 5, 9, 15, 17, 20, 27, 31, 34, 36, 39, 43, 46, 47, 51, 54, 60 | prednisone (1), xylaropyrone (2), 19,20-epoxy cytochalasin C or derivative (9, 15, 17), rottlerin (31), naringin (34), animicin A (47) |
| X. subintraflava | SWUF17-24.2 | 1, 2, 3, 6, 9, 14, 17, 29, 34, 36, 39, 43, 46, 47, 49, 60 | prednisone (1), xylaropyrone (2), 19,20-epoxy cytochalasin C or derivative (9, 17), rottlerin (29), naringin (34), animicin A (47), tiliroside (49) |
| X. thienhirunae | SWUF16-7.2 | 1, 2, 3, 8, 11, 24, 32, 60 | prednisone (1), xylaropyrone (2) |
| X. thienhirunae | SWUF16-10.1 | 1, 2, 3, 11, 16, 19, 25, 60 | prednisone (1), xylaropyrone (2), colchicine (19) |
| X. thienhirunae | SWUF17-44.1 | 1, 2, 3, 13, 19, 60, 61 | prednisone (1), xylaropyrone (2), lagochilin (13), colchicine (19) |
| X. siamensis | SWUF17-20.2 | 1, 2, 3, 21, 40, 48, 60 | prednisone (1), xylaropyrone (2) |
| X. vinacea | SWUF18-2.3 | 1, 2, 3, 4, 7, 10, 18, 22, 28, 37, 41, 42, 45, 53, 60 | prednisone (1), xylaropyrone (2), 11-alpha-acetoxyprogesterone (10), andrographolide (22), tofisopam (28) |
Publisher’s Note: MDPI stays neutral with regard to jurisdictional claims in published maps and institutional affiliations. |
© 2021 by the authors. Licensee MDPI, Basel, Switzerland. This article is an open access article distributed under the terms and conditions of the Creative Commons Attribution (CC BY) license (https://creativecommons.org/licenses/by/4.0/).
Share and Cite
Wangsawat, N.; Nahar, L.; Sarker, S.D.; Phosri, C.; Evans, A.R.; Whalley, A.J.S.; Choowongkomon, K.; Suwannasai, N. Antioxidant Activity and Cytotoxicity against Cancer Cell Lines of the Extracts from Novel Xylaria Species Associated with Termite Nests and LC-MS Analysis. Antioxidants 2021, 10, 1557. https://doi.org/10.3390/antiox10101557
Wangsawat N, Nahar L, Sarker SD, Phosri C, Evans AR, Whalley AJS, Choowongkomon K, Suwannasai N. Antioxidant Activity and Cytotoxicity against Cancer Cell Lines of the Extracts from Novel Xylaria Species Associated with Termite Nests and LC-MS Analysis. Antioxidants. 2021; 10(10):1557. https://doi.org/10.3390/antiox10101557
Chicago/Turabian StyleWangsawat, Niwana, Lutfun Nahar, Satyajit D. Sarker, Cherdchai Phosri, Andrew R. Evans, Anthony J. S. Whalley, Kiattawee Choowongkomon, and Nuttika Suwannasai. 2021. "Antioxidant Activity and Cytotoxicity against Cancer Cell Lines of the Extracts from Novel Xylaria Species Associated with Termite Nests and LC-MS Analysis" Antioxidants 10, no. 10: 1557. https://doi.org/10.3390/antiox10101557
APA StyleWangsawat, N., Nahar, L., Sarker, S. D., Phosri, C., Evans, A. R., Whalley, A. J. S., Choowongkomon, K., & Suwannasai, N. (2021). Antioxidant Activity and Cytotoxicity against Cancer Cell Lines of the Extracts from Novel Xylaria Species Associated with Termite Nests and LC-MS Analysis. Antioxidants, 10(10), 1557. https://doi.org/10.3390/antiox10101557

